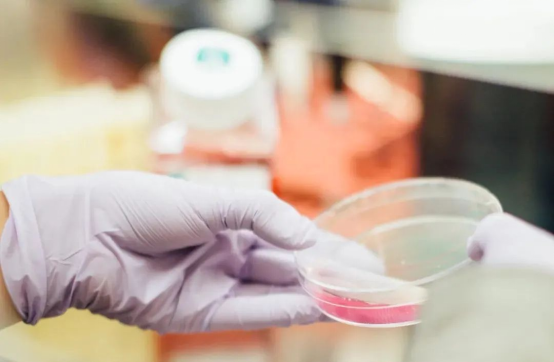
image.png

12月份Sungo实验室开设了四期线上直播课程,感谢大家的关注及参与!
如果您错过了12月份的课程,不要急,后续还会有更多的线上课程等您来,关注沙格公众号,第一时间获取培训课程消息动态!
由于课程时间有限,有许多学员们提出的问题讲师未能一一回答。于是我们收集了课程中大家提出的问题并做出了解答,希望能帮助到您!
Q1
买的定量菌株如何验收?
答:
验证外包装是否完整,菌种信息是否齐全,再根据产品说明书,验证它的菌落形态,可采用麦士比浊法、吸光度法(细菌的浓度与OD600nm呈正比关系)或菌液逐级稀释法确定菌浓度是否在需求范围内。
Q2
如何保证菌的浓度在100CFU?
答:
比如验证的培养物菌浓度为3.0×108CFU/mL,逐级稀释6次后,试管为3.0×102CFU/mL,再从试管内吸取0.3mL加入培养基内即可。
Q3
为什么优先选用薄膜过滤法?
答:
薄膜过滤法是针对有抑菌成分的供试品可以过滤掉抑菌成分,操作过程是全封闭操作,不易于被污染。
还能提高检测效率避免试管浑浊,改善培养周期出现碱性环境等问题,提高细菌污染的可能性。

Q4
薄膜过滤法会容易产生假阳性吗?
答:
不容易产生假阳性。利用直接接种法可能会造成假阳性现象,薄膜过滤法可有效地去除溶液当中的微生物,避免试管浑浊。
Q5
薄膜过滤法中如何判断供试品具有抑菌作用?
答:
首先确定产品的方法适用性检查,采用薄膜过滤法时,在产品方法适用性检查的过程中,供试品过滤后,根据冲洗量不同:
冲洗100ml、300ml、400ml、500ml等,再分别加入不大于100CFU的阳性菌,做一个阳性对照。
培养后,观察供试品培养器与阳性对照培养器浑浊程度是否有差异,若无差异,则没有抑菌成分;若有差异,则有抑菌成分。
再选择不同冲洗量冲洗滤膜,如果其中一个培养器与阳性对照浑浊程度大概一致,可确定此冲洗量可以去除抑菌成分。

Q6
无菌检查法观察时出现浑浊,新鲜培养基也出现浑浊,就能确认产品有菌吗?
答:
不能,还需要进行挑菌、涂布、镜检后,判断菌是否为供试品所含。如果不是,可视为人为操作带进去的。实验无效。
Q7
无菌两种培养基需各一个阳性对照吗?
答:
根据产品特性,选择一个阳性对照菌就可以。这个阳性对照菌加在相应的培养基内。